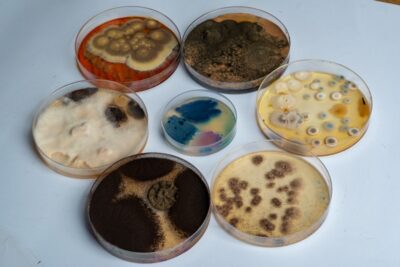

Med povzročitelje težav na dihalih vsekakor uvrščamo tudi glive oz. plesni. Pogosto gre za glive iz rodu Aspergillus, zlasti vrste fumigatus. Ta je razširjena po vsem svetu, je vseprisotna in stiku z njenimi sporami se težko ognemo. Zanimiv je pripetljaj s to plesnijo in maskami v Švici. Zaradi kontaminacije s plesnijo so leta 2020 zavrgli skoraj 14 milijonov dihalnih mask, ki so izvirale iz vojaških zalog in jih je zvezna vlada dala na voljo glavnim distributerjem in kantonom. Poglejmo torej, kakšne težave ta plesen oz. gliva lahko povzroča? Kako pridemo z njo v kontakt? Kaj obolenje povzroča in kako težave razlikujemo od prehlada in njegovih zapletov ter alergije na cvetni prah?
Med povzročitelje težav na dihalih vsekakor uvrščamo tudi glive oz. plesni. Pogosto gre za glive iz rodu Aspergillus, zlasti vrste fumigatus. Ta je razširjena po vsem svetu, je vseprisotna in stiku z njenimi sporami se težko ognemo. Zanimiv je pripetljaj s to plesnijo in maskami v Švici. Zaradi kontaminacije s plesnijo so leta 2020 zavrgli skoraj 14 milijonov dihalnih mask, ki so izvirale iz vojaških zalog in jih je zvezna vlada dala na voljo glavnim distributerjem in kantonom. Poglejmo torej, kakšne težave ta plesen oz. gliva lahko povzroča? Kako pridemo z njo v kontakt? Kaj obolenje povzroča in kako težave razlikujemo od prehlada in njegovih zapletov ter alergije na cvetni prah?
Kaj je aspergiloza?
Gre za glivično obolenje, povzročeno z nitasto glivo Aspergillus. Najpogosteje obolenje povzroča patogena vrsta plesni Aspergillus fumigatus. Prizadene predvsem dihala, zlasti obnosne votline in pljuča. Redko so ob hujših primerih obolenja prizadeti drugi organski sistemi – koža, nohti, prebavila, ledvice, srce ali centralni živčni sistem. Pod nazivom aspergiloza se skriva več različnih težav s to plesnijo. Poglejmo nekatere od njih.
Alergijska bronhopulmonalna aspergiloza (ABPA)
Alergijska bronhopulmonalna aspergiloza (ABPA)
Je alergijska reakcija telesa na naselitev spor plesni v pljučih. Običajno se pojavlja pri ljudeh z obstoječo astmo ali cistično fibrozo. 1–2 % astmatikov naj bi imela okužbo s to plesnijo. Pri okuženih med drugim prevladuje poslabšanje astme s ponavljajočimi pojavi oteženega dihanja, vročine, slabosti in izkašljevanjem rjave ali krvave sluzi. Oteženo dihanje ni vedno prisotno. Lahko pa okuženi tudi ne čuti nič od navedenega.
Invazivna aspergiloza
Za to obliko je značilno zelo hitro širjenje iz pljuč v ožilje, kožo, srce, ledvice in možgane. Velja za najhujšo obliko aspergiloze. Simptomi so odvisni od tega, kateri del je prizadet; lahko se pojavlja vročina, mrzlica, izkašljevanje krvi, krvavitve iz nosu, kratka sapa, bolečine v prsih in sklepih, glavobol, težave z očmi in lezije po koži. Zbolijo osebe, ki so imunsko zelo oslabljene. Raziskovalci opozarjajo, da se ta oblika aspergiloze zaradi vse več oseb, ki jemljemo zdravila za zaviranje delovanja imunskega sistema, vse bolj povečuje. Če sumite na to okužbo, ukrepajte takoj in poiščite ustrezno pomoč.
Saprofitna aspergiloza
Ta oblika se razvije redko in je pogosto prikrita. V tem primeru gliva tvori aspergilom. To je sferična tvorba plesni, ki poleg njenih nitastih hif vsebuje še sluz in odmrle celice. Ta “gobja kroglica” se razvije na primer v nosnih sinusih ali pljučih, pogosto na mestih predhodnih poškodb (npr. v luknjicah pljuč, nastalih zaradi tuberkuloze, emfizema ali drugih obolenj). RTG slikanje lahko razkrije tvorbo in pojasni krvavo izkašljevanje, ki se ob teh težavah lahko pojavi. Sicer lahko obolenje sprva poteka brez simptomov in če se ne odkrije, lahko kasneje povzroča kašelj z izkašljevanjem krvi, kihanje, kratko sapo, hujšanje in utrujenost.

Druge oblike aspergiloze
Poleg površinske oblike aspergiloze, ki prizadene imunsko oslabele osebe, in sicer njihovo kožo, zunanji sluhovod in nohte, pa te plesni lahko povzročajo težave tudi sinusom. Znaki okužbe zgornjih dihal so podobni hujšemu prehladu – lahko se pojavijo zamašen nos, izcedek iz nosu, ki lahko vsebuje kri, vročina, bolečina na obrazu in glavobol.
Aspergillus pa lahko povzroči tudi mikotoksikozo – zastrupitev, ki jo povzročajo toksini, ki jih vsebuje plesen.
Kako pridemo s sporami v kontakt?
Plesni oz. glive ustvarjajo spore, jih spuščajo v zrak ter se tako širijo in razmnožujejo. Oboleli se okuži predvsem z vdihavanjem spor iz zraka, čemur se je zaradi vsesplošne prisotnosti plesni težko izogniti. Plesni najdemo tako v zunanjem kot notranjem okolju, zato se z njimi lahko srečujemo tako rekoč vsak dan.
Najdemo jih npr.:
- V zemlji, kjer razkrajajo organski material, v kompostnem kupu, na rastlinah, v vodi.
- V vlažnih, zatohlih prostorih stavb, kot so kleti, kopalnice, garaže, od poplav poškodovani objekti, na gradbiščih.
- Na vlažnih stenah, kotičkih oken, kjer se pozimi nabira kondenz, na stenah za omarami, ker se slabo zračijo, v zemlji sobnih rastlin, v zraku, na tleh oz. v prahu, ki se nahaja na raznih slabo dostopnih površinah, na starih knjigah, v pralnem stroju in posledično na oblekah.
- V prezračevalnih sistemih naših domov, hipermarketov, bolnišnic.
- Na starem sadju, zelenjavi, kruhu, suhem sadju, pivu, vinu, kavi.
- Na žitih, oreščkih, začimbah.
- Na dihalnih maskah.

Kaj je potrebno za obolenje?
Čeprav je Aspergillus fumigatus zelo razširjena, pa zboli razmeroma malo ljudi. Če ste zdravi in imate močan imunski sistem, vam ni treba skrbeti. Vaš imunski sistem bo spore plesni, ki jih vsak dan vdihujemo, učinkovito obvladal in izločil iz telesa.
Drugače je pri osebah, ki že trpijo zaradi hujših obolenj, kot je astma, KOPB, avtoimunske bolezni, cistična fibroza, ciroza jeter, diabetes, rak, AIDS in druga. Prav tako so za obolenje dovzetnejše osebe na kemoterapiji, zaviralcih imunskega sistema, kortikosteroidih in, med drugim, pogostih terapijah z antibiotiki. Spremenjen mikrobiom dihal, kot kaže, prav tako lahko vpliva na večjo dovzetnost za okužbo. Ogroženi so lahko tudi tisti, ki gredo na presaditev organa, kakšno drugo večjo operacijo ali so zaradi obolenja (npr. kovida) sprejeti v bolnišnico. Za nastanek obolenja je torej potreben oslabljen ali umetno zatrt imunski sistem, kar odpre vrata sporam plesni globlje v telo. Ocenjuje se, da vsako leto samo zaradi okužbe z Aspergillusom umre do 600.000 ljudi po vsem svetu.
V kolikor imate astmo ali cistično fibrozo, pri težavah z dihanjem obiščite zdravnika, da se aspergiloza izključi. V primeru oslabljenega imunskega sistema in razvoja nepojasnjene vročine, oteženega dihanja, izkašljevanja krvi, nemudoma poiščite pomoč, saj gre lahko za invazivno obliko aspergiloze, ki se hitro razvija. Hitro zdravljenje je nujno.
Kako vemo, da ne gre za prehlad, zaplet prehlada ali alergijo na cvetni prah?
O razlikovanju prehladnih obolenj in alergij na cvetni prah si lahko več preberete v prispevku: Ali je prehlad ali že alergija. Za zaključek pa poglejmo še nekaj idej, kako ju razlikovati od težav, povezanih z aspergilozo. Seveda se za natančnejšo potrditev, ali gre res za okužbo s problematično plesnijo, obrnite na ustreznega strokovnjaka.
Težav z aspergilozo verjetno nimate, če je vaš imunski sistem na splošno močan. Če imate hujša obolenja, ste prestali težjo operacijo, ste imunsko oslabljeni, starejši oz. imate zdravila, ki zavirajo imunski sistem, je večja verjetnost, da je v ozadju težav, ki spominjajo na prehlad ali seneni nahod, aspergiloza. Slednja je še verjetnejša, če ste bili dlje časa izpostavljeni okolju, kjer je lahko veliko spor plesni – če ste na primer vdihovali prah na gradbišču.

Da gre za prehlad, vemo, če ta traja par dni do enega tedna in nato simptomi izzvenijo. Simptomi nahoda, kašljanja, solzenja se pri prehladu razvijajo počasi eden za drugim. Pri kontaktu z alergenom (sporami plesni ali pelodi rastlin) pa se lahko simptomi pojavi vsi naenkrat. Pri alergijah na pelode ali plesni običajno ne čutimo rahlih bolečin v telesu kot pri prehladu.
Če se prehlad zakomplicira v bakterijsko okužbo, lahko obolenje dihal traja tudi več tednov. Po ustrezni terapiji simptomi, ki spremljajo takšno vnetje dihal, izzvenijo. Če kašelj, težko dihanje, sinuzitis nikakor ne prenehajo in je terapija z antibiotikom neučinkovita, je dobro pomisliti tudi na okužbo s plesnimi.
Simptomi alergije na cvetni prah se pojavljajo v obdobju, značilnem za cvetenje posamezne alergene rastline. Katera vam povzroča težave, lahko preverjate s koledarjem cvetenja alergenih rastlin. Če se alergija ne pokriva s koledarjem cvetenja alergenih rastlin, gre lahko za alergijo na plesni. Ta je lahko pogojena tako sezonsko kot prisotna celoletno.
Solzenje, kihanje, sinuzitis, oteženo dihanje, kašljanje zaradi pelodov je posebej intenzivno ob lepem in suhem vremenu, ko je cvetenje najbolj bujno in je peloda v zraku veliko. A simptomi alergije na pelode se običajno umirijo v deževnem obdobju, ko dež spere cvetni prah iz ozračja. Če je draženje enako močno tudi ob deževnem vremenu, je lahko posredi alergija na plesni. Plesni imajo rade vlago, zato v takšnem vremenu proizvajajo še več spor.
Besedilo: Adriana Dolinar
Viri:
Attention mycose! Reconnaître et traiter l’aspergillose, Claudia Rawer, www.avogel.ch
Saprophytic Aspergillosis, Dr R Grech MD et al
Airborne Aspergillus fumigatus conidia: a risk factor for aspergillosis. Céline M. et al.


 Pokličite nas
Pokličite nas
 Strani za stroko
Strani za stroko